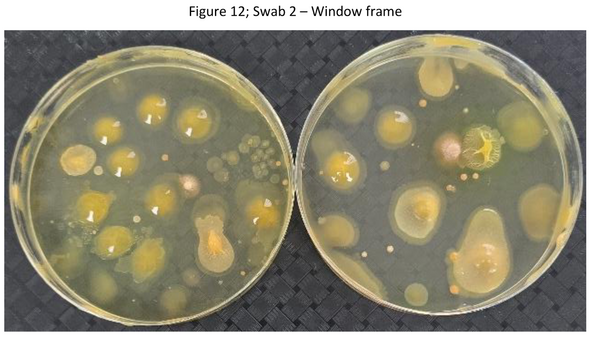

EXCLUSIVE: Each house boasts home windows however this surprising examine has discovered they are often tons of of occasions filthier {that a} public bathroom.
Microbiologists learning the state of UK properties have been appalled to search out how unwashed window frames can boast 300-times MORE micro organism than a public bathroom seat. Specialists at blinds and curtains agency Hillarys partnered with microbiologist Reynold Mpofu, from Coventry-based BioLabTests, to conduct a examine to see simply how soiled home windows can get in the event that they’re not cleaned often.
One-third (30%) of UK householders admit to by no means cleansing them, a behavior which could possibly be turning our home windows into hidden hotspots for germs. To their horror, on the pattern properties they examined, they discovered window frames the filthiest with higher than or equal to fifteen,000 CFUs (colony-forming unit) – no less than 300-times extra micro organism than a public bathroom seat (50 CFUs).

A window deal with swab take a look at outcome (Picture: Hillarys)
A CFU is a single viable cell or group of cells that multiply to type a colony on a development medium – utilized by scientists to estimate the variety of dwelling microbes in a pattern, essential for microbiology, meals security, and probiotics.
Window handles have been additionally closely contaminated (14,000 CFUs), additionally indicating a big bacterial build-up.
Pores and skin micro organism equivalent to Staphylococcus have been recognized on home windows, in addition to a faecal bacterium, E. coli, which is usually present in public loos.
The window body swab evaluation additionally confirmed essentially the most development for each yeast and mold – with some surfaces examined have been considerably dirtier than these sometimes discovered on the London Underground.
Whereas closely used Tube handrails have been proven to hold round 1,600 micro organism, the worst surfaces on this take a look at carried shut to fifteen,000 – round eight occasions extra.
Discussing the findings with Hillarys, Mpofu mentioned: “For folks with bronchial asthma, allergy symptoms, eczema or weakened immune programs, this mixture of mould spores, mud and faecal micro organism will be sufficient to spark respiratory irritation, pores and skin flare-ups or infections.”
Youthful adults (18–24) are the worst for curtain cleansing, as 28% admit they’ve by no means cleaned them.
Staphylococcus and E. coli are largely discovered within the atmosphere and on pores and skin, within the nostril, mouth, lungs and digestive tracts – with people a serious organism reservoir.
Microbiologist Reynold Mpofu mentioned: “Whereas it’s unimaginable for arms to be fully freed from microbes, among the micro organism they carry may cause acute or persistent sickness.
“With many individuals avoiding or not completely washing their arms, micro organism can survive and thrive on door handles, particularly below the precise situations.
“Staphylococcus aureus and Staphylococcus epidermidis from the pores and skin, Streptococcus species from the mouth and respiratory tract, and faecal-associated micro organism equivalent to E. coli and Enterococcus are among the many many micro organism generally discovered on the deal with.”
Species recognized: E. coli (signifies faecal contamination); Yeast and mold (may cause respiratory irritation) and Staphylococcus (may cause an infection and survive in a dry atmosphere for hours to months).
One of many examine’s window body swab checks (Picture: Hillarys)
The right way to hold window frames, handles, and curtains clear:
Yvonne Keal, senior product supervisor at Hillarys, supplied key suggestions for cleansing window frames, handles and curtains.
She mentioned: “To wash window frames and handles, the best choice is to make use of heat, soapy water on a non-abrasive, smooth material.
“At all times examine the fabric of your window frames and handles, as this may decide the precise cleansing agent and methodology that may sufficiently clear the surfaces and stop injury.
“Start by eradicating any free grime or particles with a smooth brush or a brush attachment in your vacuum.
“Wash and wipe the window frames and handles with a light resolution of heat soapy water, making certain to begin from the highest and work your method down.
“Corners and handles have a tendency to construct up essentially the most grime and grime, so pay shut consideration to those smaller areas that may find yourself missed.
“As soon as accomplished, rinse completely with a clear material and water to take away all cleaning soap and stop streaks, and guarantee all surfaces are fully dry.
“Whatever the materials of your window frames, at all times keep away from utilizing abrasive cleansing supplies, harsh chemical compounds or ammonia-based cleaners.”
In the case of curtains she advised: “Cleansing curtains is usually uncared for or seen as pointless, however it may be important for stopping a bacterial build-up of mould and mud, which may trigger respiratory points.
“It’s at all times advisable to often vacuum the curtains utilizing an acceptable attachment to take away any mud that has gathered.
“A handheld steamer can then assist to take away any creases and clean up the material, however that is depending on the fabric of your curtains.
“If your private home suffers from frequent condensation, this might end in a build-up of mould on the curtain lining. Mould may be very troublesome to take away successfully with out discolouring material, so it’s critical to take preventative measures.
Suggestions and tips to assist with cleansing, laundry and heating your own home plus chosen affords and competitions Subscribe Invalid e-mail
We use your sign-up to supply content material in methods you have consented to and to enhance our understanding of you. This will likely embrace adverts from us and third events based mostly on our understanding. You possibly can unsubscribe at any time. Learn our Privateness Coverage
“Firstly, at all times hold your room heat and well-ventilated. Easy measures equivalent to opening a window might help scale back the unfold of mould.
“For rooms which are significantly vulnerable to dampness, it’s a good suggestion to spend money on a dehumidifier to assist stop dampness and enhance air high quality.”















Leave a Reply